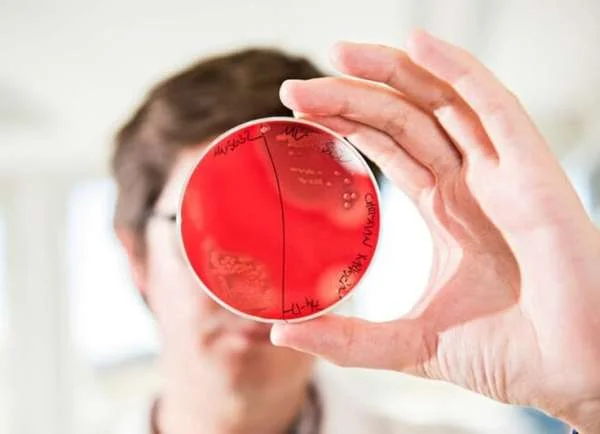
Hành Trình Kỳ Diệu: Khám Phá Bí Mật của Microbiome Đường Ruột Cá

Sáng Tạo Nông Dân: Nuôi Cá Lồng Gặt Lợi Nhờ Du Lịch Sinh Thái Ở Sơn Hà, Quảng Ngãi
Mô hình nuôi cá kết hợp du lịch sinh thái của HTX Nông nghiệp Thương mại và Dịch vụ Hiệp Phát ở huyện Sơn Hà, Quảng Ngãi, đã mang lại nhiều lợi ích không chỉ cho nông dân mà còn cho du lịch sinh thái trong khu vực. Dựa vào vị trí đắc địa của hồ chứa nước Nước Trong và sự phối hợp hài hòa giữa nuôi cá và phát triển du lịch, mô hình này đang tạo ra thu nhập ổn định và cơ hội việc làm mới cho cư dân địa phương.
1. Khám Phá Vị Thế Địa Lý Đặc Điểm:
Hồ Chứa Nước Nước Trong:
Công trình hồ chứa nước Nước Trong, với diện tích lưu vực 46km2, dung tích 289 triệu m3, đã đóng vai trò quan trọng trong cấp nước tưới cho hệ thống thuỷ lợi và phát điện. Hồ này cũng là nơi triển khai mô hình nuôi cá lồng, tận dụng nguồn lợi thuỷ sản phong phú từ sự bổ sung giống của Sở Nông nghiệp và Phát triển Nông thôn.
Tiềm Năng Du Lịch Sinh Thái:
Với cảnh sắc tuyệt vời và nền văn hóa dân dụ đặc sắc, HTX đã đầu tư trang thiết bị an toàn để phục vụ du khách. Những chuyến thuyền ngắm cảnh quanh lòng hồ và các hoạt động giải trí như tắm suối, thưởng thức ẩm thực địa phương đang thu hút du khách.
2. Mô Hình Nuôi Cá Kết Hợp Du Lịch Sinh Thái:
Giống Cá và Quy Mô Nuôi:
HTX đã được cấp phép triển khai mô hình nuôi cá lồng trên lòng hồ với các giống cá như cá lăng, cá chình, cá thác lác, và cá điêu hồng. Quy mô nuôi hiện đang là 3 lồng, với kế hoạch mở rộng lên 7 lồng trong thời gian tới.
. Hiệu Quả Kinh Tế:
Mô hình nuôi cá lăng nha thương phẩm trong lồng đã mang lại thành công, với sản lượng hơn 3,8 tấn và doanh thu gần 540 triệu đồng sau 8 tháng. Mức giá bán ổn định là 140,000 đồng/kg, đồng thời giảm chi phí và tăng hiệu quả sản xuất.. Chăm Sóc và Quản Lý Mô Hình:
Đàn cá được thả vào lồng bè để sinh sống tự nhiên, và những người dân trong khu vực, là thành viên của HTX, đảm bảo không gian nuôi an toàn và không lo mất mát. Mô hình này không chỉ mang lại lợi nhuận kinh tế mà còn giúp cộng đồng phát triển chuyên nghiệp và hiệu quả.
3. Phát Triển Du Lịch Sinh Thái:Tận Dụng Cảnh Đẹp Nhiên Nhiên:
Bên cạnh nuôi cá, HTX còn tận dụng cảnh sắc đẹp ở khu vực để phát triển du lịch sinh thái. Các hoạt động như thuê thuyền và thưởng thức ẩm thực dân dụ địa phương đang thu hút du khách.
Chia Sẻ Lợi Nhuận và Hợp Tác Cộng Đồng:
Cộng đồng chủ thuyền và chủ bè cá đều là thành viên HTX, tạo nên một phong cách làm ăn chuyên nghiệp và chất lượng. Kế hoạch mở rộng còn đưa thêm người bản địa vào HTX để tăng cường sức mạnh cộng đồng và phát triển du lịch sinh thái.
4. Triển Vọng Tương Lai và Hỗ Trợ Chính Sách:
Kế Hoạch Phát Triển:
HTX đang xin cấp giấy phép thuê toàn bộ lòng hồ để vừa nuôi cá, vừa phát triển du lịch sinh thái. Kế hoạch mở rộng số lồng nuôi và kết nạp thêm thành viên cộng đồng địa phương đang tạo ra triển vọng tương lai tích cực.
. Hỗ Trợ Chính Sách:
Sở Nông nghiệp và Phát triển Nông thôn Quảng Ngãi đã cam kết hỗ trợ HTX với 4 lồng nuôi để triển khai nuôi cá thác lác và cá lăng trong lòng hồ Nước Trong. Điều này giúp tăng cường nguồn lực và khích lệ các HTX tham gia mô hình.